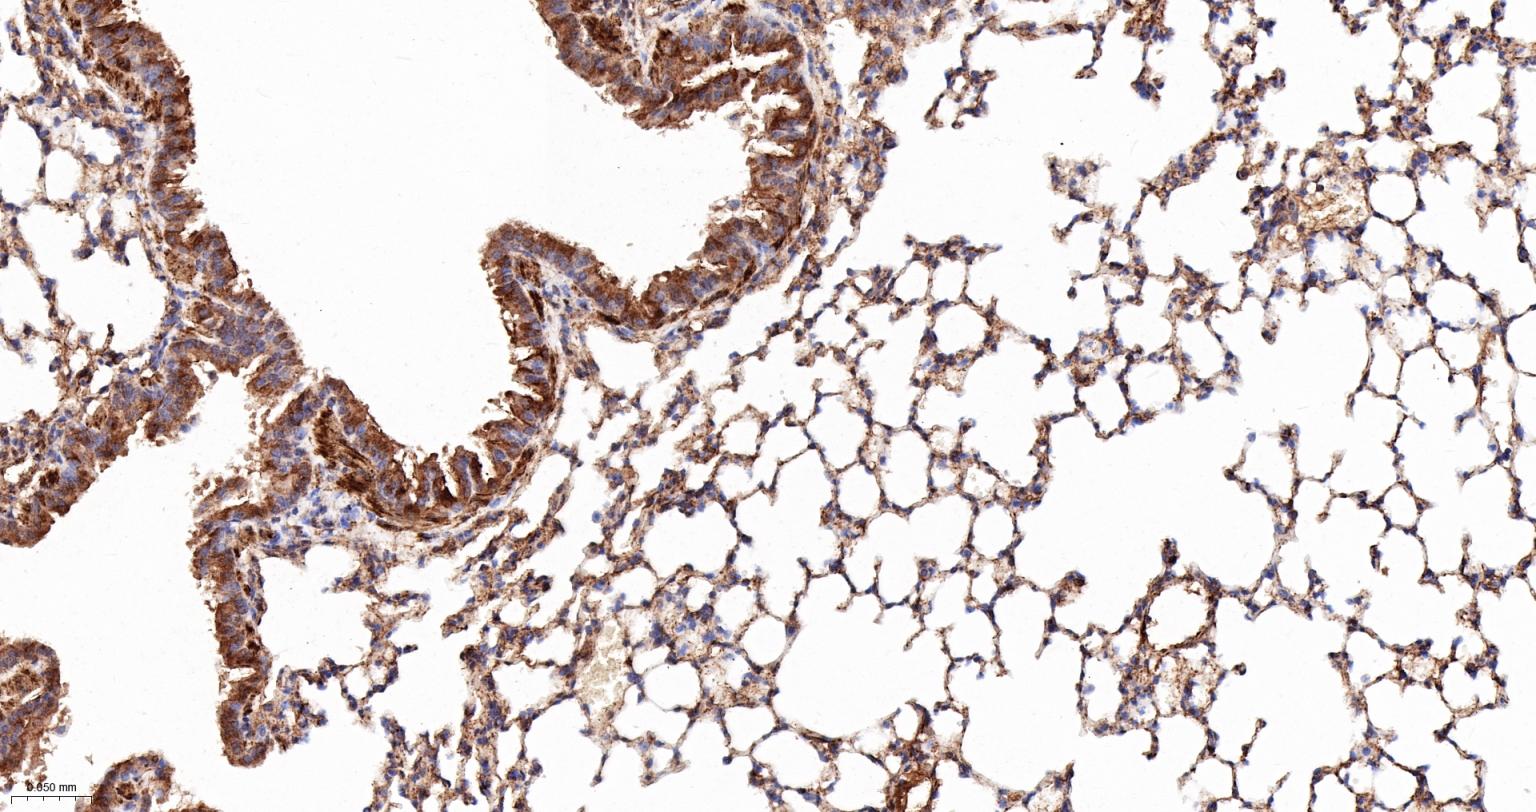
AKT1S1 Recombinant Rabbit mAb (一抗) - IHC-P,IHC-F,IF,Flow-Cyt,ICC/IF,IP | Bioss

AKT1S1 Recombinant Rabbit mAb (一抗) - IHC-P,IHC-F,IF,Flow-Cyt,ICC/IF,IP | Bioss
Rrmab?兔单抗

货号:bsm-61149R
产品详情
相关标记
相关产品
相关文献
常见问题
概述
产品编号
bsm-61149R
产品类型
重组兔单抗
英文名称
AKT1S1 Recombinant Rabbit mAb
中文名称
蛋白激酶AKT底物1重组兔单抗
英文别名
Lobe; PRAS40; 1110012J22Rik; Lobel; AKTS1_HUMAN; AKT1S1; 40 kDa proline-rich AKT substrate; AKTS1_MOUSE; Proline-rich AKT substrate; Pras;
抗体来源
Rabbit
免疫原
A synthesized peptide derived from human AKT1S1: 150-200/256
亚型
IgG
性状
Liquid
纯化方法
affinity purified by Protein A
克隆类型
Recombinant
克隆号
10H1
理论分子量
27 kDa
检测分子量
40 kDa
储存液
10mM phosphate buffered saline(pH 7.4) with 150mM sodium chloride, 0.05% BSA, 0.02% Proclin300 and 50% glycerol.
研究领域
SWISS
Gene ID
保存条件
Store at 4℃ for short term. Store at -20℃ for long term. Avoid repeated freeze/thaw cycles.
注意事项
This product as supplied is intended for research use only, not for use in human, therapeutic or diagnostic applications.
数据库链接
背景资料
Negative regulator of the mechanistic target of rapamycin complex 1 (mTORC1), an evolutionarily conserved central nutrient sensor that stimulates anabolic reactions and macromolecule biosynthesis to promote cellular biomass generation and growth.

产品应用
| 应用 | 已检合格种属 | 预测种属 | 推荐稀释比例 |
|---|---|---|---|
| IHC-P | Mouse | Human | 1:100-500 |
| IHC-F | Mouse | Human | 1:100-500 |
| IF | Mouse | Human | 1:100-500 |
| Flow-Cyt | Human | Mouse | 1:50-100 |
| ICC/IF | Human | Mouse | 1:50-200 |
| IP | Human, Mouse | 1:20-50 |
交叉反应
交叉反应: Human, Mouse
相关产品
暂无相关产品
靶标
基因名
AKT1S1
蛋白名
Proline-rich AKT1 substrate 1
亚基
Part of the mammalian target of rapamycin complex 1 (mTORC1) which contains MTOR, MLST8, RPTOR, AKT1S1/PRAS40 and DEPTOR. mTORC1 binds to and is inhibited by FKBP12-rapamycin. Interacts directly with RPTOR. The phosphorylated form interacts with 14-3-3 proteins.
亚细胞定位
Cytoplasm, cytosol.
组织特异性
Widely expressed with highest levels of expression in liver and heart. Expressed at higher levels in cancer cell lines (e.g. A-549 and HeLa) than in normal cell lines (e.g. HEK293).
翻译后修饰
Phosphorylated by AKT1. Phosphorylation relieves inhibitory function on mTORC1.
相似性
Belongs to the ubiquitin-conjugating enzyme family.
功能
Subunit of mTORC1, which regulates cell growth and survival in response to nutrient and hormonal signals. mTORC1 is activated in response to growth factors or amino-acids. Growth factor-stimulated mTORC1 activation involves a AKT1-mediated phosphorylation of TSC1-TSC2, which leads to the activation of the RHEB GTPase that potently activates the protein kinase activity of mTORC1. Amino-acid-signaling to mTORC1 requires its relocalization to the lysosomes mediated by the Ragulator complex and the Rag GTPases. Activated mTORC1 up-regulates protein synthesis by phosphorylating key regulators of mRNA translation and ribosome synthesis. mTORC1 phosphorylates EIF4EBP1 and releases it from inhibiting the elongation initiation factor 4E (eiF4E). mTORC1 phosphorylates and activates S6K1 at 'Thr-389', which then promotes protein synthesis by phosphorylating PDCD4 and targeting it for degradation. Within mTORC1, AKT1S1 negatively regulates mTOR activity in a manner that is dependent on its phosphorylation state and binding to 14-3-3 proteins. Inhibits RHEB-GTP-dependent mTORC1 activation. Substrate for AKT1 phosphorylation, but can also be activated by AKT1-independent mechanisms. May also play a role in nerve growth factor-mediated neuroprotection.
同靶标产品
相关文献
提示: 发表研究结果有使用 bsm-61149R 时请让我们知道,以便我们可以引用参考文章。作为回馈,资料提供者将获得我们送上的小礼品。